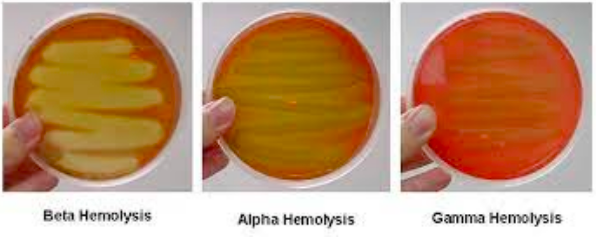

1
Q
5 características comunes de los streptococcus
A
- cocos
- gram positivos
- catalasa negativo
- anaerobios facultativos
- parejas (diplococos) o en cadenas
2
Q
3 formas de clasificar a los streptococcus
A
- patrón hemolítico
- propiedad serológica (grupo de Lancefield)
- resistencia o sensibilidad a antibióticos (optoquina/bacitracina)
3
Q
Clasificación por su patrón hemolítico
A
- incompleta: alfa (verde)
- completa: beta (blanco)
- ausencia de hemólisis: gamma (rojo)
4
Q
Clasificación por sus propiedades serológicas
A
- Grupo A (GAS) → pyogenes
- Grupo B (GBS) → agalactiae
5
Q
Streptococcus sensible a la optoquina
A
s. pneumoniae
6
Q
Streptococcus resistente a la optoquina
A
s. viridians
7
Q
Streptococcus sensible a la bacitracina
A
s. pyogenes
8
Q
Streptococcus resistente a la bacitracina
A
s. agalactiae


